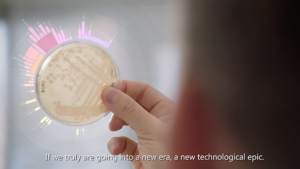
Microsoft - Social Technical Collaboratory

Our work spans across the full spectrum of Strategic Video Content Creation.
Television commercials. Corporate Brand videos. Conceptual stories. Product launch videos. Feature Documentary story telling, long and short form. We customize our clients strategic content to the multiple platforms they need to share it on. This assures their content is always optimally received by their target audience.